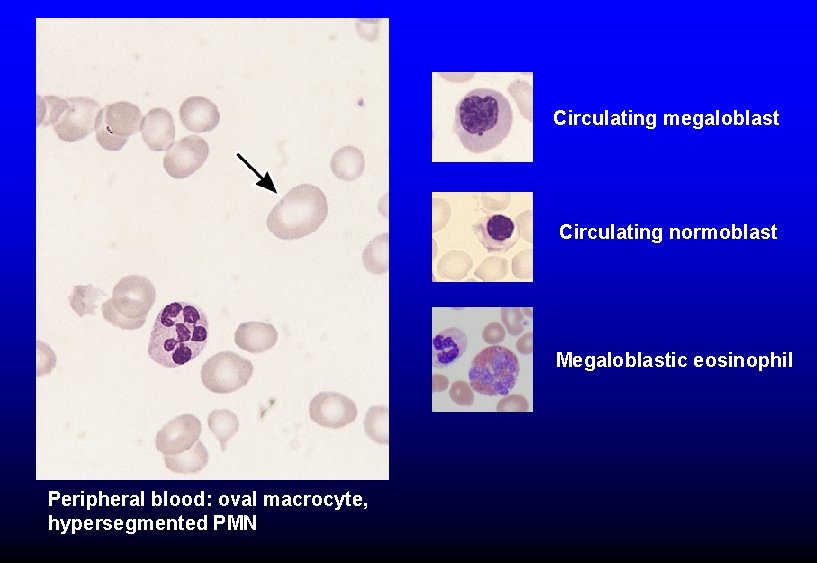

B12 AND FOLATE DEFICIENCY MEGALOBLASTIC ANEMIAS MACROCYTIC VS

B-12 AND FOLATE DEFICIENCY MEGALOBLASTIC ANEMIAS

MACROCYTIC VS MEGALOBLASTIC ANEMIA Macrocytic: MCV >95 -100 Megaloblastic: delayed nuclear maturation

MACROCYTIC VS MEGALOBLASTIC ANEMIA Causes of macrocytosis – Liver disease – Alcoholism – Reticulocytosis – Hypothyroidism – Aplastic anemia – Myelodysplasia – Drugs that block DNA synthesis – B-12 and folate deficiency Megaloblastic
Circulating megaloblast Circulating normoblast Megaloblastic eosinophil Peripheral blood: oval macrocyte, hypersegmented PMN

Bone marrow: giant band (black arrow), megalobasts at various stages of differentiation (red Normal erythroid precursors

normal megalo

B 12 deficiency → increased homocysteine and methylmalonate Folate deficiency → increased homocysteine

B-12 deficiency “traps” folate in methyl. TH 4 form, unavailable for thymidine synthesis Tetrahydrofolate required for thymidine synthesis and hence for DNA synthesis

© Nicholas V. Cozzi, Ph. D Enzymatic reactions that use folates. BG Katzung, SB Masters, AJ Trevor. Basic and Clinical Pharmacology, 12 th

VITAMIN B-12 • Dietary sources: meat, poultry, fish; typical intake 7 -30 μg/day, 2 -3 μg absorbed • Stomach acid enhances absorption from food; intrinsic factor (from gastric parietal cells) facilitates absorption in ileum • Absorbed vitamin bound to transcobalmin II and transported to marrow • Normal body stores 2000 -3000 μg (biologic half-life about 1 yr) • Clinical disease associated with B-12 deficiency when stores < 20% of normal

B-12 Absorption 1. Dietary B-12 transferred from food to binding protein (R-binder or haptocorrin) in stomach. Stomach acid needed. 2. Intrinsic factor (IF) made by gastric parietal cells 3. Pancreatic enzymes degrade R-binders in duodenum; B-12 transferred to IF 4. B-12/IF complex binds to receptor (cubulin) in distal ileum 5. B-12 absorbed, IF broken down NO INTRINSIC FACTOR → ↓↓ B-12 ABSORPTION

Blood 2017; 129: 2603 © Nicholas V. Cozzi, Ph. D

CAUSES OF B-12 DEFICIENCY • Insufficient intake (strict vegetarians/vegans) Ø Failure of absorption – Lack of intrinsic factor: autoimmune (“pernicious anemia”), gastrectomy, (rare) inherited deficiency of IF – Pancreatic insufficiency (rare cause) – Lack of ileal absorption: Crohn’s, small bowel resection – Competition for vitamin by intestinal bacteria (eg “blind loop” syndrome) or tapeworm • Genetic lack of transcobalmin II (rare) • Destruction of B-12 by nitrous oxide

Autoimmune destruction of parietal cells causes B-12 deficiency 3. T-cells kill parietal cells, no intrinsic factor or acid produced 1. Dendritic cells in stomach clear apoptotic parietal cells 2. Dendritic cells in paragastric nodes activate Tcells directed against ATPase expressed in parietal cells NEJM 2014; 370: 773

Hematologic improvement with liver extract (lots of B-12) or “stomach juice” (source of intrinsic factor) given orally in patients with pernicious anemia Castle WB. Am J Med Sci 1929 (from NEJM 2014; 370: 773)

© Nicholas V. Cozzi, Ph. D

AUTOIMMUNE DEFICIENCY OF B-12 “PERNICIOUS ANEMIA” • • Antibodies to parietal cells (sensitive test) Antibodies to intrinsic factor (specific test) Permanent loss of B-12 absorption Achlorhydria, gastric atrophy (not corrected by B-12 replacement)

B-12 DEFICIENCY BLOOD AND MARROW FINDINGS • Megaloblastic anemia • WBC and platelets may be low (pancytopenia) • Low serum B-12 level, increased methylmalonate and homocysteine • Marrow cellular with low G: E ratio, megaloblastic changes in rbc and granulocyte series • Retic count not increased (ineffective erythropoiesis) • High LDH and bilirubin due to red cell precursor breakdown in marrow (in advanced disease)

Hypercellular marrow, erythroid hyperplasia, megaloblastic erythropoiesis, giant band (arrow) Normal marrow

B-12 DEFICIENCY OTHER CONSEQUENCES • Neurologic injury (esp loss of vibratory sense & proprioception) – Advanced disease may not be completely reversible – Giving folate to B-12 deficient pt may correct/prevent anemia, but make neurologic deficits worse • Neural tube defects (in pregnancy) • Glossitis

Figure 4. 4. Degeneration of the posterior and lateral columns of the spinal cord in vitamin B 12 deficiency. The arrows point to areas of demyelination and loss of nerve fibers. (From Kass, LS: Pernicious anemia. Phila. , WB Saunders Co. , 1976. )

B-12 December 1982 April 1983 Courtesy of Dr. Robert Schilling

FOLIC ACID • MW 400 • Yeast, vegetables, dairy products, seafood good dietary sources (but vitamin can be destroyed by cooking) • Absorbed in jejunum (50 -80% of dietary vitamin absorbed) • Normal intake 200 -250 mcg/day, requirement 100 mcg/day • Body stores 10 -12 mg • Biologic half-life about one month – Stores can be depleted if RBC production demand high • Needed for thymidine synthesis, amino acid metabolism, purine metabolism

FOLATE DEFICIENCY Causes • • Poor diet Celiac disease Pregnancy (increased utilization) Increased rbc production (chronic hemolysis – increased utilization) • Alcoholism (poor diet, poor absorption, poor storage if liver injured) • Anticonvulsants (phenytoin) decrease absorption

FOLATE DEFICIENCY Clinical and laboratory findings • Megaloblastic anemia with ineffective erythropoiesis (typically less severe than advanced B-12 deficiency) • WBC and/or platelets may be low • No neurologic injury • Mild maternal deficiency → neural tube defects • Low serum folate level – RBC folate level does not provide additional useful information • Increased serum homocysteine, normal methylmalonate

B-12 AND FOLATE DEFICIENCY Cause B-12 Folate Decreased intake Strict vegetarians and vegans Alcoholism Malnutrition Malabsorption Absence of intrinsic factor Blind loop Pancreatic insufficiency Resection of terminal ileum Drugs Generalized malabsorption Increased utilization/loss Very rare • Pregnancy • Hemolysis Drug inhibition Nitrous oxide Methotrexate Genetic defects Transcobalmin II (rare) Even rarer
- Slides: 26